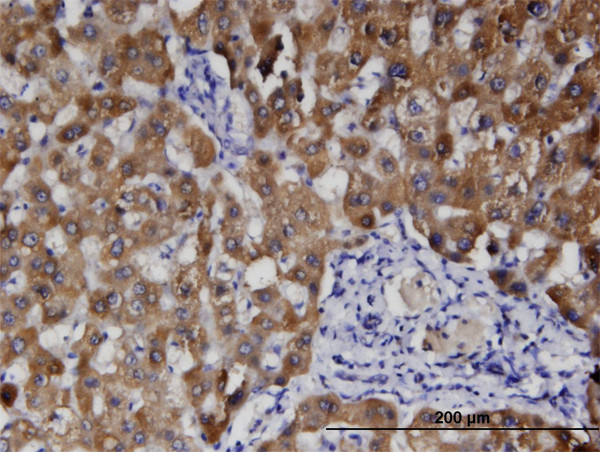
HFE2 Antibody in Immunohistochemistry (Paraffin) (IHC (P))

Search
Abnova
HFE2 Monoclonal Antibody (1C12)
{{$productOrderCtrl.translations['antibody.pdp.commerceCard.promotion.promotions']}}
{{$productOrderCtrl.translations['antibody.pdp.commerceCard.promotion.viewpromo']}}
{{$productOrderCtrl.translations['antibody.pdp.commerceCard.promotion.promocode']}}: {{promo.promoCode}} {{promo.promoTitle}} {{promo.promoDescription}}. {{$productOrderCtrl.translations['antibody.pdp.commerceCard.promotion.learnmore']}}
产品信息
H00148738-M01
宿主/亚型
分类
类型
克隆号
抗原
偶联物
形式
浓度
规格
保存条件
运输条件
产品详细信息
Sequence of this protein is as follows: GGCPPSQRLS RSERNRRGAI TIDTARRLCK EGLPVEDAYF HSCVFDVLIS GDPNFTVAAQ AALEDARAFL PDLEKLHLFP S
靶标信息
HFE2 is involved in iron metabolism. It may be a component of the signaling pathway which activates hepcidin or it may act as a modulator of hepcidin expression. It could also represent the cellular receptor for hepcidin. Alternatively spliced transcript variants encoding different isoforms have been identified for this gene. Defects in this gene are the cause of hemochromatosis type 2A, also called juvenile hemochromatosis (JH). JH is an early-onset autosomal recessive disorder due to severe iron overload resulting in hypogonadotrophic hypogonadism, hepatic fibrosis or cirrhosis and cardiomyopathy, occurring typically before age of 30.
仅用于科研。不用于诊断过程。未经明确授权不得转售。